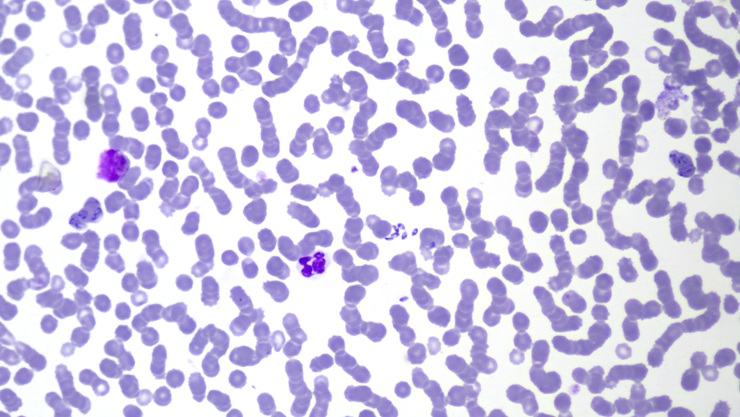
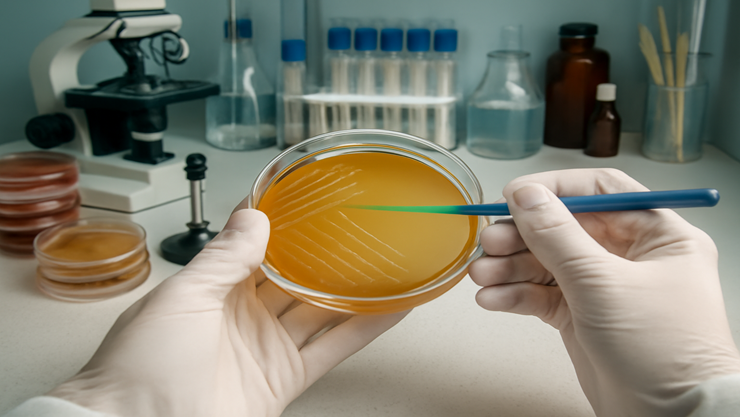

Veterinary Diagnostic Laboratory
We are proud to be a trusted partner in the veterinary community, and we are committed to providing exceptional care to all our clients and their beloved pets.
Welcome to VetProDx Veterinary Diagnostics
At VetProDx Veterinary Diagnostics, we understand that accurate diagnostics are the foundation of effective clinical decision-making. We provide high-quality clinical pathology services to veterinary clinics and hospitals that prioritize evidence-based medicine.
Founded by Dr. Shivam Mandhare (MVSc Pathology), VetProDx was born out of a passion for clinical pathology and a recognition of the growing need for dedicated, reliable diagnostic support in the veterinary field. With years of hands-on experience and a commitment to excellence, Dr. Shivam brings not only technical expertise but also a deep understanding of the challenges faced by clinicians.
What sets us apart is our emphasis on collaboration and clarity. We go beyond just delivering results — we work closely with veterinarians to ensure every report is not only accurate but also insightful and clinically relevant. Our approach minimizes misinterpretation and helps drive better patient outcomes.
At VetProDx, our mission is simple: to make diagnostics simple, reliable, and insightful. By building strong clinic-pathologist communication, we aim to support every veterinary professional in delivering the best care possible.
We’re here not just as a lab, but as your diagnostic partner.
Welcome to VetProDx Diagnostics
Welcome to our veterinary diagnostic laboratory, where we provide reliable and accurate diagnostic services for all your animal healthcare needs. Our laboratory is staffed by a team of experienced and highly skilled professionals who are dedicated to providing exceptional care to your pets.
- High Accuracy
- Fast Sample Collections
- In Time Report
Address
101, Krishnakunj Building, Besides Shanti Sadan CHS, Majiwada, Thane (W)
Phone
+91-8999688418
Opening hours
Mon - Sat
09:30 am - 22:00 pm
Our Services
We have certified technician who work with us.
Hematology and Biochemistry analysis
Blood and serum tests to assess cells, organ function, and metabolism.

Cytology
Microscopic examination of cells to detect abnormalities or diagnose diseases.

Histopathology
Microscopic study of tissue samples to diagnose diseases and abnormalities.
Microbiology
Study of microorganisms to identify infections and guide appropriate treatment.

Lateral-flow immunochromatography assays
Rapid tests detecting specific antigens or antibodies using capillary action.

Other
Miscellaneous diagnostic tests supporting comprehensive disease detection and health assessment.
Get in touch with us!
Our Clients








Our Reviews
Client's Feedback
“VetProDx was quick, professional, and super helpful with my dog’s tests. The staff was friendly and explained everything clearly. Great service!”
“As a vet, I trust VetProDx for fast, accurate results. Their reports are clear, and the team is always responsive. Highly recommended.”
“I loved how easy it was to schedule the test and get results fast. The online portal is very user-friendly. I’ll definitely return!”
“Reliable and efficient! My clinic uses VetProDx regularly and their team is top-notch in both communication and diagnostics.”
Feel free to contact us.
admin@vetprodx.com
Call us
+918999688418
Reach to us via our location
View Map


